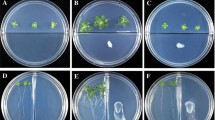

Abstract
Aims
The colonization of plant growth-promoting rhizobacteria (PGPR) along plant roots in turn facilitates their ability to promote plant growth and health. In this study, we found that Bacillus subtilis strain WM13-24 from the rhizosphere of Haloxylon ammodendron was able to promote the growth of both Arabidopsis and its host plant. Furthermore, we found that volatile organic compounds (VOCs) from strain WM13-24 could promote plant growth by stimulating lateral root formation and root hair growth. However, the molecular mechanism underlying WM13-24-stimulated root development is still unknown.
Methods
In this study, a series of Arabidopsis mutants defective in specific plant hormone signaling pathways were used as materials to preliminarily study the effect of VOCs released by strain WM13-24 on plant root development through genetic and pharmacological methods. The volatile compounds of strain WM13-24 were identified by solid-phase microextraction gas chromatography-mass spectrometry (SPME–GC–MS).
Results
WM13-24 was able to promote the growth of both Arabidopsis and its host plant, H. ammodendron. Auxin signaling and transport played a crucial role in WM13-24-stimulated changes of root architectures in Arabidopsis. SPME–GC–MS analysis revealed that WM13-24 produces various classes of compounds. We further showed that 2,3-butanediol and benzyl alcohol were active in promoting plant growth and the growth responses of plants to the two VOCs were concentration dependent.
Conclusions
All these results suggested that VOCs emitted from B. subtilis strain WM13-24 from the rhizosphere of H. ammodendron improves root development depending on auxin signaling.
Similar content being viewed by others
Avoid common mistakes on your manuscript.
Introduction
Terrestrial plants harbor a highly complex microbiota community in soil closely adhering to their rhizosphere. The rhizosphere provides a niche for interactions between plant roots and microbes (Bulgarelli et al. 2013; Sasse et al. 2018; Qu et al. 2020). Root-associated soil bacteria or fungi can strongly influence plant fitness (Vílchez et al. 2020). Some beneficial bacteria or fungi living in the rhizosphere are referred to as plant growth-promoting rhizobacteria or fungi (PGPR or PGPF), which promote plant growth by inducing the adaptive development of vigorous root systems and enhancing the capacity of the host plants to acquire nutrients and water from the soil (Verbon and Liberman 2016). The production of bioactive metabolites in microbes is strain-dependent and these metabolites include volatile (Ryu et al. 2003; Garnica-Vergara et al. 2016; Cordovez et al. 2018; Camarena-Pozos et al. 2019; Syed-Ab-Rahman et al. 2019; Li et al. 2021) and nonvolatile substances (Wang et al. 2020; Sun et al. 2020; Inaji et al. 2020). The microbial volatile organic compounds (VOCs) database contains thousands of listed VOCs from a wide range of microbes, as well as proposed metabolomic pathways (https://bioinformatics.charite.de/mvoc/) (Lemfack et al. 2018). Microbial volatile compounds diffuse freely into the environment through aqueous solutions and permeate through the atmosphere, this means volatile compounds have important roles as signals in intra-kingdom and inter-kingdom communication at low concentrations and over long distances (Ryu et al. 2003; Bailly and Weisskopf 2017; Schulz-Bohm et al. 2017; Piechulla et al. 2017; Syed-Ab-Rahman et al. 2019; Raza et al. 2021). These volatile compounds of low molecular weight (< 300 Da) belong to a broad range of chemical classes such as aldehydes, ketones, alkyls, alcohols, esters, alkynes, acids, sulfur and nitrogen-containing compounds (Kai et al. 2009; Xu et al. 2015; Garbeva and Weisskopf 2020). Plants either take up VOCs as nutrient sources or perceive them as infochemicals (Meldau et al. 2013; Bailly et al. 2014; Matsui 2016; Aziz et al. 2016; Zhou et al. 2016; Morcillo et al. 2020).
Roots play important roles in the growth and development for plants (Lv et al. 2021). The root system of dicots is formed by one embryonically formed primary root and post-embryonically developed lateral roots (LRs) of different orders (Du and Scheres 2018; Jia et al. 2021). Lateral roots (LR) formation involves priming, initiation, patterning and emergence (Malamy and Benfey 1997; Péret et al. 2009). It is well known that many PGPR and PGPF strains caused alterations in the root system architecture of plants by promoting the formation of lateral root and root hair and resulted in enhanced plant growth (Zamioudis et al. 2013; Garnica-Vergara et al. 2016; Sun et al. 2020; Li et al. 2021). PGPR modified root system architecture and the structure of root tissues mainly through interfering with the homeostasis and signaling of endogenous plant hormones, such as auxin, cytokinin, gibberellin, ethylene (ETH), brassinosteroid, jasmonic acid (JA) and abscisic acid (ABA) (Osmont et al. 2007; Sharifi and Ryu 2018). Therefore, root system growth are complex processes that are modulated by a variety of phytohormones and signaling molecules (Van de Poel et al. 2015). Auxin in plant fulfils multiple roles throughout LR development (Péret et al. 2009; Du and Scheres 2018). Auxin distribution is regulated mainly by auxin transport proteins, including members of the AUXIN 1/Like AUXIN (AUX1/LAX) family of influx carriers and PIN-FORMED (PIN) proteins of efflux carriers (Adamowski and Friml 2015; Chen et al. 2015; Li et al. 2020).
The increased root development leads to an increased root surface that could improve plant nutrition and thus would be a key factor for plant growth promotion by PGPR. Bacillus sp. was found in association with roots of many different plants (Cazorla et al. 2007; Beauregard et al. 2013; Li et al. 2021). Exposure of Arabidopsis seedlings to VOCs emitted by Bacillus sp. increased root branching and biomass production (Ryu et al. 2003; López-Bucio et al. 2007; Hossain et al. 2019; Li et al. 2021). Thus, VOCs-dependent plant growth and development is apparently under control of complex mechanisms, although its signaling components have remained largely unidentified. In this study, a volatile producing Bacillus subtilis strain from the rhizosphere of H. ammodendron was used to investigate its growth promotion effect on both Arabidopsis and its host plant. Then, the physiological and molecular mechanism underlying root development effect was probed and we investigated how this strain induced Arabidopsis mutants defective in phytohormone signaling. We found that Bacillus subtilis WM13-24 was able to promote the growth of both Arabidopsis and its host plant. B. subtilis WM13-24 inoculation altered the root architecture of Arabidopsis by increasing the number of lateral roots and elongating root hairs. Auxin signaling and transport participated in WM13-24 induced plant root development.
Materials and methods
Suspension culture of the bacterial strains
Bacillus amyloliquefaciens GB03 (Ryu et al. 2003), Bacillus subtilis WM13-24 and Escherichia coli strain DH5α were cultured on LB medium (composition in gram per liter: tryptone 10; yeast extract 5; NaCl 10, pH = 7) without light for 24 h at 28 °C or 37 °C (DH5α). Cells of PGPR strain WM13-24 were harvested from LB medium in distilled water to yield 109 (OD = 600) colony forming units (CFU) mL−1, as determined by optical density and serial dilutions.
Plant materials and growth conditions
For the in vitro assays, Arabidopsis thaliana ecotype Col-0 was used as the wild type to compare with the mutants, including axr1 (Estelle and Somerville 1987), axr2 (Timpte et al. 1994), axr4 (Hobbie and Estelle 1995), eir1 (Roman et al. 1995), cre1 (Inoue et al. 2001), etr1 (Hua and Meyerowitz 1998), gai (Stotz et al. 2011), cbb1 (Kauschmann et al. 1996), coi1-1 (Xie et al. 1998), and NahG (Lawton et al. 1995) transgenic plants were used in this study.
The arf7-1 mutant and DR5::GUS transgenic plant line were presented by Dr. Hong-Ju Yin at Lanzhou University, China. The mutants of arf19-1, arf7arf19, ein3-1 and jar were presented by Prof. Lai-Sheng Meng in Jiangsu Normal University, Xuzhou, China. The mutant of aux1-7 was presented by Dr. Hai-Qing Liu at Lanzhou University, China. The PIN1::PIN1::GFP, PIN2::PIN2::GFP, PIN4::PIN4::GFP and PIN7::PIN7::GFP transgenic plant lines were presented by Prof. Chuan-You Li in Chinese Academy of Sciences, China.
Seeds were surface-sterilized with 75% (v/v) ethanol for 3 min and 1% sodium hypochlorite (v/v) for 5 min, washed eight times with sterile water. Seeds were vernalized for 3 days at 4 °C in darkness. Petri plates were prepared by adding 1/2 Murashige and Skoog (MS) agar medium (1/2 MS salts, 1% sucrose, and 0.75% agar, pH 5.7). Unless otherwise indicated Arabidopsis plants were cultured in Petri dishes containing sucrose-free solid MS. In the divided Petri plates (I-plates), bacterial suspension was applied drop wise in one of the compartments and Arabidopsis seeds were sown in the other compartment.
To investigate the effects of volatile compounds (benzyl alcohol) in Arabidopsis, the 1.5 mL short thread vial (Beijing Labgic Technology Co., Ltd) contained benzyl alcohol with concentrations of 50 μM, 100 μM, 200 μM, 500 μM, 750 μM, 5000 μM, mixture compounds of benzyl alcohol and 2,3-butanediol with concentrations of 50 μM + 50 μM, 50 μM + 100 μM, 50 μM + 200 μM, 100 μM + 50 μM, 100 μM + 100 μM, 100 μM + 200 μM, and solvent controls contained water. The vial was placed in one of the compartment and five Arabidopsis thaliana seeds were grown in the other compartment. The Petri dishes were transferred and positioned vertically in a growth chamber under a long-day photoperiod (16 h of light, with light intensity of 100 μmol m−2 s−1) at 22 ± 1 °C.
For pot experiments, seeds of H. ammodendron were collected from wild plants in Alxa League Right Banner (39.2513° N; 101.54697° E), Inner Mongolia Autonomous Region, China (Lü et al. 2019). The sterilized seeds were sown in plastic pots (5 × 5 × 5 cm; 10 seedling/pot) containing heat-sterilized vermiculite (H. ammodendron) and half strength Hoagland nutrient solution for growth (Gao et al. 2020). When plants reached four weeks-old, they were divided into two groups, inoculation bacterial suspension group and VOCs treatment group. Each pot of H. ammodendron was inoculated with 5 mL bacterial suspension culture of WM13-24 or water as control. For VOCs treatment experiment, six pots of H. ammodendron were transplanted to sealed containers (8 L, 6 pots). The container contained half strength Hoagland nutrient solution and 1.5 mL vials (100 μM benzyl alcohol, 500 μM 2,3-butanediol, both 100 μM benzyl alcohol and 500 μM 2,3-butanediol, respectively), which were added every two days. The plant growth promotion parameters were typically assessed at 14 d after treatment. Plants were grown in greenhouse under 28/23 °C (day/night), the photoperiod was 16/8 h (light/dark) and the light intensity was 1200 μmol photons m−2 s−1 under metal halide and high-pressure sodium lamps, and the relative humidity was about 70%.
Each pot of Arabidopsis was inoculated with bacterial suspension culture of WM13-24 or water as control. The plant growth promotion parameters were typically assessed at 14 d after treatment. Plants were grown as described above.
Quantification of shoot and root growth
For shoot and total fresh weight measurements, seedlings were immediately measured on an analytical balance. The method for measurement leaf chlorophyll content was the same as described by He et al. (2018).
Photographs were taken with a digital camera (Cannon EOS 7D, Cannon Inc., Japan). Primary root (PR) length was measured using a ruler. Lateral root (LR) density was calculated with LR number divided by the PR length of each seedling. Total root length was determined using a root scan apparatus (Perfection V700Photo, Seiko Epson Corp., Japan) equipped with WinRHIZO software (Regent Instruments Inc., Canada). The specific procedure was the same as described by Wang et al. (2016).
Histochemical staining and microscopy
Wild type Arabidopsis Col-0 and transgenic line DR5::GUS were immersed in staining buffer (50 mM K3Fe(CN)6, 50 mM K4Fe(CN)6 3H2O, 1 M Na2HPO4, 1 M NaH2PO4, 0.25 M Na2EDTA, Trifonx-100, methanol, ddH2O, 2 mM X-Gluc) and incubated overnight at 37 °C. Seedlings were cleared in consecutive washes 75% (v/v) ethanol. Images were obtained using fluorescence microscope (DM6 B, Leica, Germany).
Microscopy
The number of emerged LR and images of the root hair were obtained using stereomicroscope (M205 A, DMC5400, Leica, Germany). Green fluorescence from roots of DR5::GFP was observed under a fluorescence microscope (DM6 B, DFC2000T, Leica, Germany) and PIN::GFP transgenic plants were observed under a laser scanning confocal microscope (SP8 SR, Leica, Germany).
RNA isolation and qRT-PCR
Total RNA was isolated using RNAiso Plus Kit (TaKaRa) in accordance with the manufacturer’s protocol. Gene expressions in Arabidopsis were analyzed by qRT-PCR with SYBR Green dye (SYBR® Green Real-time PCR Master Mix-Plus, Code No. QPK-212) and performed on an ABI StepOnePlus Real-Time PCR System. AtActin2 was used as internal control. The relative expression levels of all these genes were gained using the 2−△△CT method. The primers used are listed in supporting information Table S1.
Measurement of IAA content
Under control and strain WM13-24 treatment, roots of 12-day-old seedlings were collected for measurement of IAA content. The IAA content was determined using the method described by He et al. (2021). Briefly, fresh samples were soaked in 80% methanol, then the supernatant was collected and extracted with an equal volume of ethyl acetate, finally the dried samples containing IAA was dissolved in the mobile phase, and the dissolved sample was determined by RIGOL HPLC L-3000. The extracts of each treatment were repeated three times.
Analysis of VOCs by SPME–GC–MS
The VOCs released by WM13-24 were analyzed in Petri dishes containing 1/2 MS medium with a solid-phase microextraction (SPME) technique and GC–MS. The compounds were collected for 15 h with gray SPME fiber (Carboxen/DVB/PDMS, 2 cm, 50/30 μm; Agilent, USA) and desorbed at 230 ℃ for 5 min in the injector port of a gas chromatograph (Agilent 7890D, USA), equipped with an MS detector (7000D, USA), and the MassHunter Workstation software for data acquisition and processing.
Agilent DB1701 capillary column (30 m × 0.25 μm × 0.25 μm) was used. Helium was used as the carrier gas at a flow rate of 1 mL min−1. The column was maintained at 35 ℃ for 3 min at the beginning, then was programmed to 180 ℃ at a rate of 3 ℃/min, further to 230 ℃ at 25 ℃/min, and ultimately held for 5 min. The mass fragments were analysed using electron impact ionization at 70 eV. The compounds were identified by comparison with mass spectra from NIST. Only compounds with the match > 700 were taken and compared with the mass spectra of the NIST/EPA/NIH Mass Spectral Library version (NIST14.L). There were four treatments shown as follows: 1/2 MS medium (control), 1/2 MS medium contains 14 days-old Arabidopsis, co-cultivation of 14 days-old Arabidopsis and bacterium WM13-24 and 1/2 MS medium only contains bacterium WM13-24.
Statistical analysis
Growth and physiological parameters were presented as means with standard errors (n ≥ 3). All data were subjected to one-way analysis of variance (ANOVA) and Duncan’s multiple comparison test or student's t test were used to detect the significant differences among means at a significance level by SPSS 19.0 (SPSS Inc., Chicago, IL, USA).
Results
Effect of B. subtilis WM13-24 on seedling growth of Arabidopsis and H. ammodendron and root development of Arabidopsis
Inoculation with strain WM13-24 was found to promote biomass production of Arabidopsis in vitro and in soil. Strain WM13-24 at three densities (OD600 = 0.5, 0.8 and 1) significantly increased shoot dry weight (120%, 160% and 190%, respectively), root dry weight (93%, 120% and 150%, respectively), leaf chlorophyll a (14%, 32% and 43%, respectively) and chlorophyll b content (12%, 28% and 39%, respectively) (P < 0.05) of Arabidopsis compared to control (Fig. 1A, B, C). Correspondingly, under OD600 of 0.5 and 1, strain WM13-24 significantly (P < 0.05) increased plant photosynthetic rate by 33% and 51%, respectively (Fig. 1D). In addition, strain WM13-24 significantly (P < 0.05) increased total fresh weight of H. ammodendron seedlings growth in pots containing vermiculite by 17% and 35% and total dry weight by 30% and 25% 14 and 40 days after inoculation of strain WM13-24 under OD600 of 0.8, respectively, compared to control (Fig. 2).
Effects of the inoculation of B. subtilis WM13-24 on the growth of Arabidopsis in the pots. Plant growth performance (Scale bar, 5 cm) (A). Plant dry weight (B), Chlorophyll contents (C) and photosynthesis rate (D) were measured 14 days after inoculation. Values are means and bars indicated standard errors (SEs) (n = 10). Columns with different letters indicated significant difference at P < 0.05 (ANOVA and Duncan’s multiple comparison test)
Effects of the inoculation of B. subtilis WM13-24 on the growth of Haloxylon ammodendron in the pots. Plant growth performance (Scale bar, 5 cm) (A). Plant fresh weight (B) and dry weight (C) were measured 14 or 40 days after inoculation. Values are means and bars indicated standard errors (SEs) (n = 10). “*” indicated significant differences at P < 0.05 (t test)
Then, the effects of WM13-24 on Arabidopsis seedling growth and root development were evaluated in sterile plates (Fig. 3A). Strain WM13-24 significantly increased the number of lateral root (LR) by 41% (P < 0.05) 14 days after inoculation, compared to control (Fig. 3B). In addition to positive effects on LR formation, WM13-24 had a strong impact on root hair development (Fig. 3C). B. subtilis WM13-24 showed the similar growth promotion effect on Arabidopsis compared to B. amyloliquefaciens GB03 as shown in Fig. S1.
Effects of VOCs released from B. subtilis WM13-24 on root architecture of Arabidopsis. Plant growth performance (Scale bar, 3 cm) (A). Lateral root (LR) number (B) and the distance from the last growing root hair to root tip (Scale bar, 1 mm) (C) were measured 14 days after inoculation of B. subtilis WM13-24 and sowing of the seeds of Arabidopsis. Values are means and bars indicated standard errors (SEs) (n = 10). “*” indicated significant differences at P < 0.05, and “**” indicated significant differences at P < 0.01 (t test)
Screening Arabidopsis-signaling pathway mutants for regulatory control of root development
In order to probe the mechanism by which bacterial volatiles can regulate root development, PGPR strain WM13-24 was tested against a series of Arabidopsis mutants defective in specific regulatory pathways, and total root length, LR number and LR density were analyzed at 14 days. The mutants included ein3-1 and etr1 for ethylene, cre1 for cytokinin, gai for gibberellin acid, jar and coi1 for jasmonic acid, cbb1 for brassinosteroid, NahG for salicylic acid. As showed in Fig. 4, these mutants (ein3-1, etr1, cre1, gai, jar, coi1, cbb1 and NahG) responded to VOCs like Col-0 by increasing total root length (187%, 63%, 30%, 119%, 38%, 160%, 120% and 77%, respectively) (Fig. 4B), LR number (77%, 73%, 28%, 94%, 41%, 43%, 47% and 32%, respectively) (Fig. 4C) and lateral root density (73%, 67%, 29%, 64%, 56%, 35%, 59% and 33%, respectively) (P < 0.01) (Fig. 4D) 14 days after inoculation. Although strain WM13-24 also promoted root development in the cytokinin receptor mutant cre1 to a certain extent, the effect was much lower than that of the wild type Col-0.
Effects of VOCs released from B. subtilis WM13-24 on the growth of Arabidopsis mutants (ein3-1, etr1, cre1, gai, jar, coi1, cbb1 and NahG). Plant growth performance (Scale bar, 3 cm) (A). Total root length (B), LR number (C) and lateral root density (number of emerged lateral roots cm.−1) (D) were measured 14 days after inoculation of B. subtilis WM13-24 and sowing of the seeds of Arabidopsis. Total root length was observed using a root scan apparatus (Perfection V700Photo, Seiko Epson Corp, Japan) equipped with WinRHIZO software (Regent Instruments Inc., Canada). Values are means and bars indicated standard errors (SEs) (n = 20). “*” indicated significant differences at P < 0.05, and “**” indicated significant differences at P < 0.01 (t test)
To further address the role of auxin signaling in WM13-24-induced root development, we analyzed the responses of Col-0 and Arabidopsis single or double mutants (arf7, arf19, arf7arf19, axr1, axr2, axr4 and eir1) defective in auxin signaling to VOCs emitted from strain WM13-24 (Fig. 5A). The arf19, axr1, axr4 and eir1 mutants, which formed a significantly reduced total root length under control treatment, responded to VOCs emitted from strain WM13-24 with increased total root length, but only approximately 45%, 40%, 46% and 58% of that of WM13-24-treated Col-0, respectively (Fig. 5B). However, the double mutant arf7arf19 did not respond to the VOCs without increased total root length (Fig. 5B). The VOCs increased LR number of arf7, arf19, axr1, axr2, axr4 and eir1 mutants by 209%, 88%, 25%, 21%, 39% and 11% (P < 0.01), respectively, compared to their individual control, however, was not capable of rescuing the LR-defective phenotype of the arf7arf19 mutant, whose lateral root formation is completely abolished (Fig. 5C).
Effects of VOCs released from B. subtilis WM13-24 on the growth of Arabidopsis mutants (arf7, arf19, arf7arf19, axr1, axr2, axr4 and eir1). Plant growth performance (Scale bar, 3 cm) (A). Total root length (B), LR number (C) and lateral root density (number of emerged lateral roots cm.−1) (D) were measured 14 days after inoculation of B. subtilis WM13-24 and sowing of the seeds of Arabidopsis. Total root length was observed using a root scan apparatus (Perfection V700Photo, Seiko Epson Corp, Japan) equipped with WinRHIZO software (Regent Instruments Inc., Canada). Values are means and bars indicated standard errors (SEs) (n = 20). “*” indicated significant differences at P < 0.05, and “**” indicated significant differences at P < 0.01 (t test)
Effect of B. subtilis WM13-24 VOCs on auxin response of Arabidopsis
LR formation is tightly correlated with auxin signaling (Fukaki et al. 2007). To investigate the role of auxin response in WM13-24 VOCs-induced LR formation, transgenic plants harbouring DR5::GUS and auxin-responsive marker DR5::GFP were used. WM13-24 VOCs enhanced the expression of the GUS in the entire root, especially in the lateral root primordia, compared with control (Fig. 6A). Similarly, the VOCs also increased the green fluorescence level of GFP in the apical meristem and lateral root (Fig. 6D). To investigate how the development of LRP (lateral root primordia) is affected by WM13-24, the developmental stage of each LRP on WM13-24-treated roots was classified according to Malamy and Benfey (1997). Stage I: The first evidence of LRP initiation is the appearance of closely spaced cell walls in the pericycle layer in perpendicular orientation to the root axis. Stage II: A periclinal division occurs that divides the LRP into two layers (outer layer and inner layer). Stage III: The outer layer divides periclinally, generating a three-layer primordium comprising outer layer 1, outer layer 2 and inner layer. Stage IV: The inner layer divides periclinally, creating a total of four cell layers. Stage V: A central cell in outer layer 1 and outer layer 2 divides anticlinally to form four small cuboidal cells. Stage VI: The LRP has passed through the parent cortex layer and has penetrated the epidermis. Stage VII: The LRP appears to be just about to emerge from the parent root. LRP stages I-III and VI-VII were significantly increased in strain WM13-24 VOCs treated seedlings (Fig. 6B). Strain WM13-24 VOCs significantly increased the number of total LRP by 180%, compared to control (Fig. 6C). Furthermore, the expression levels of genes related to LR formation were analyzed using qRT-PCR. The expression levels of LATERAL ORGAN BOUNDARIES DOMAIN16 (LBD16) and LBD29 were induced significantly by WM13-24 VOCs, although those of ARF7 and ARF19 were not altered (Fig. 6E).
Effects of B. subtilis WM13-24 VOCs on auxin response in Arabidopsis. Auxin responses monitored using DR5::GUS transgenic plants (Scale bar, 50 mm) (A), LRP (lateral root primordia) number at different stages (B), The total number of LRP (C), Auxin responses monitored using DR5::GFP transgenic plants (Scale bar, 5 mm) (D), The expressions of auxin signaling and lateral root growth related genes in the roots of Col-0 seedlings (E). AtActin2 was used as the reference gene. Values are means and bars indicated standard errors (SEs) (n = 3 or 12). “*” indicated significant differences at P < 0.05, and “**” indicated significant differences at P < 0.01 (t test)
Therefore, we further measured root IAA level and the expression levels of genes related to IAA biosynthesis, ASA1 (ANTHRANILATE SYNTHASE SUBUNIT 1), TAA1, YUC5, YUC8, YUC9, NIT1 (NITRILASE 1) and NIT2, and auxin dynamic balance maintenance, GH3.1 (GRETCHEN HAGEN 3.1), GH3.5 and GH3.6 (Staswick et al. 2005), using qRT-PCR. WM13-24 VOCs enhanced root IAA level by 73% compared with control (Fig. 7A). WM13-24 VOCs significantly increased the expression levels of ASA1, YUC5, YUC8, YUC9, NIT1, NIT2, GH3.1, GH3.5 and GH3.6 by 25%, 43%, 17%, 28%, 21%, 37%, 27%, 17% and 39%, compared with their individual controls (P < 0.05) (Fig. 7B). The major route of IAA biosynthesis is the indole-3-pyruvate pathway (Kasahara 2016). To confirm that WM13-24 VOCs-induced LR formation was mediated by auxin biosynthesis, we employed L-kynurenine and 4-phenoxyphenyl boronic acid to inhibit the function of TAA1/TARs and YUCs (Inaji et al. 2020), respectively (Fig. S2A). In the presence of 0.5 and 1 μM 4-phenoxyphenyl boronic acid, WM13-24 VOCs still stimulate LR formation with increased LR number, whereas in the presence of 1 μM L-kynurenine, LR formation was inhibited (Fig. S2B). The results shown that TAA1-mediated auxin biosynthesis may require for strain WM13-24 VOCs-promoted LR formation.
Effects of VOCs released from B. subtilis WM13-24 on IAA content of Arabidopsis root in split Petri dishes. IAA content (A), The expression of auxin biosynthesis related genes in the roots of Col-0 seedlings (B). AtActin2 was used as the reference gene. Values are means and bars indicated standard errors (SEs) (n = 3). “*” indicated significant differences at P < 0.05 (t test)
Effect of B. subtilis WM13-24 VOCs on auxin polar transport of Arabidopsis
In order to investigate the role of auxin transport in WM13-24 VOCs-induced lateral root formation, the LR phenotype of the auxin influx mutant aux1-7 was used (Fig. 8A). The LR number of aux1-7 was less than that of Col-0 under control condition, but WM13-24 VOCs could still increase LR number of aux1-7 by 47% (similarly by 41% for Col-0) (P < 0.05) (Fig. 8B). Furtherly, to test the possible role of auxin polar transport in WM13-24 VOCs-induced lateral root formation, the auxin efflux inhibitor 2-((1 naphthalenylamino)-carbonyl) benzoic acid (NPA) was supplemented to the plant growth media. In the presence of 1 μM NPA, WM13-24 VOCs still stimulate LR formation with increased LR number, whereas in the presence of 5 μM NPA, LR formation was completely inhibited and WM13-24 VOCs could not stimulate LR formation (Fig. 8C). Above results suggested auxin efflux was required for WM13-24 VOCs-stimulated LR formation. Thus, we analyzed the levels of four auxin efflux carriers, PIN1, PIN2, PIN4 and PIN7, in WM13-24 VOCs exposed transgenic lines expressing PIN1::PIN1::GFP, PIN2::PIN2::GFP, PIN4::PIN4::GFP and PIN7::PIN7::GFP. As shown in Fig. 9, WM13-24 VOCs obviously reduced the green fluorescence level of PIN4 and slightly reduced those of PIN1 and PIN2, whereas obviously induced that of PIN7 compared with their individual controls (Fig. 9A, B). Subsequently, the gene expression levels of above four auxin efflux carriers and auxin influx carriers, AUX1, LAX1, LAX2 and LAX3, were analyzed using qRT-PCR. The expression levels of PIN1, PIN2 and PIN4 were reduced, whereas PIN7 was induced significantly by WM13-24 VOCs, compared with their individual controls (Fig. 9C), which was consistent with the changes of their green fluorescence levels. The expression levels of AUX1, LAX1 and LAX2 were significantly reduced by WM13-24 VOCs (Fig. 9C).
Effects of auxin transport on B. subtilis WM13-24 VOCs-mediated LR formation in the Arabidopsis. Plant growth performance (Scale bar, 3 cm) (A). LR number in the auxin influx mutant aux1-7 (B) and Arabidopsis wild-type (Col-0) (C) were measured 14 days after inoculation of B. subtilis WM13-24 and sowing of the seeds of Arabidopsis. Col-0 seedlings were grown on a medium containing 0, 1 or 5 μM NPA (2-((1 naphthalenylamino)-carbonyl) benzoic acid) dissolved with DMSO (Dimethyl sulfoxide). Values are means and bars indicated standard errors (SEs) (n = 20). Columns with different letters indicated significant differences at P < 0.05 (ANOVA and Duncan’s multiple comparison test)
B. subtilis WM13-24 regulated auxin polar transport. Confocal images of Arabidopsis transgenic PIN1::PIN1::GFP, PIN2::PIN2::GFP, PIN7::PIN7::GFP (A) and PIN4::PIN4::GFP (B) seedlings of the primary root tips were photographed and the expressions of auxin carrier genes (PIN1, PIN2, PIN4, PIN7, AUX1, LAX1, LAX2 and LAX3) in the roots of Col-0 seedlings (C) were analyzed by qRT-PCR 7 days after inoculation of B. subtilis WM13-24 and sowing of the seeds of Arabidopsis. Scale bars represented 75 μm. AtActin2 was used as the reference gene. Values are means and bars indicated standard errors (SEs) (n = 3). “*” indicated significant differences at P < 0.05 (t test)
Analysis of B. subtilis WM13-24 VOCs and their effects on plant growth promotion
Solid-phase microextraction and GC–MS were used to identify volatile compounds produced by strain WM13-24 alone or WM13-24 in the interaction with Arabidopsis seedlings. A total of 18 kinds of VOCs, including alcohols, esters and others, were detected in the headspace of plates with strain WM13-24 compared with control (1/2 MS medium) or Arabidopsis seedling only (Table 1). Among these 18 kinds of VOCs, acetoin, 2,3-butanediol and benzyl alcohol were detected in the plates with WM13-24 alone (Fig. S3) and acetoin and 2,3-butanediol in the plates with WM13-24 in the interaction with Arabidopsis seedlings (Fig. S4).
2,3-butanediol has been reported to promote plant growth (Ryu et al. 2003; Perez-Flores et al. 2017; Li et al. 2021). Therefore, the effect of other compounds (α-methyl-benzeneethanol, 1-nonanol, 4-(1,1-dimethylpropyl)-cyclohexanone and 1-butanol), benzyl alcohol and mixtures of benzyl alcohol and 2,3-butanediol on plant growth were examined in this study. To determine the growth promotion effects of benzyl alcohol, the compound at various concentrations were applied to Arabidopsis (Petri dishes), respectively. The growth promotion effect of benzyl alcohol is dose-dependent (Fig. S5A). Benzyl alcohol at 50 and 100 μM significantly increased the total fresh weight of Arabidopsis seedlings by 21% and 24%, respectively, however, significantly reduced the total fresh weight by 35% and 59%, respectively, at 750 and 5000 μM (Fig. S5B). Benzyl alcohol at 50, 100, 200 and 500 μM significantly increased LR number by 43%, 68%, 52% and 22%, respectively (P < 0.05) (Fig. S5C). Benzyl alcohol at all concentrations tested significantly increased LR density (Fig. S5D).
Above result indicated that benzyl alcohol at 50 and 100 μM had the best growth promotion effect. 50 or 100 μM of benzyl alcohol mixed with 2,3-butanediol at 50, 100 or 200 μM were applied to Arabidopsis, respectively (Fig. S6A). Mixture of benzyl alcohol and 2,3-butanediol at 50 μM + 50 μM, 50 μM + 100 μM, 50 μM + 200 μM, 100 μM + 50 μM, 100 μM + 100 μM and 100 μM + 200 μM significantly increased LR number by 22%, 31%, 29%, 44%, 50% and 50% (Fig. S6C), and lateral root density by 25%, 44%, 23%, 23%, 49% and 51%, respectively (P < 0.05) (Fig. S6D). Moreover, other compounds such as α-methyl-benzeneethanol, 1-nonanol and 4-(1,1-dimethylpropyl)-cyclohexanone, detected in strain WM13-24 VOCs cannot induce LR formation tested by those pure compounds (Figs. S8, S9). 1-butanol at 100 μM increased the total fresh weight and lateral root density of Arabidopsis seedlings (Fig. S7).
Benzyl alcohol, 2,3-butanediol and their mixture were also applied to B. subtilis WM13-24’s host plant H. ammodendron to determine their growth promotion effects. Benzyl alcohol at 100 μM, 2,3-butanediol at 500 μM and their mixture at 100 + 500 μM significantly increased the total fresh weight by 13%, 9% and 7%, and total dry weight by 20%, 15% and 10%, respectively (P < 0.05) (Fig. S10).
Discussion
PGPR or PGPF colonize the plant rhizosphere and provide a number of beneficial functions for their host and induce plant systematic resistance against biotic and abiotic stresses (Zamioudis et al. 2013; Sun et al. 2020). The contribution of PGPR or PGPF can be exerted through different mechanisms including root system architecture modulation and growth promotion by production of phytohormones such as auxin or indole derivative, small molecules or volatile compounds (Spaepen et al. 2014; Verbon and Liberman 2016; Sun et al. 2020; Li et al. 2021). In current study, plant root inoculation with B. subtilis WM13-24 from the rhizosphere of Haloxylon ammodendron in pots significantly promoted the growth of both model plant Arabidopsis and its host plant H. ammodendron. By employing a germ-free experimental system, we demonstrated the possible mechanism of how VOCs released from WM13-24 promoted root development using mutants of Arabidopsis with perturbations in hormone signaling. Carbon dioxide (CO2) is released upon respiratory metabolism of animals and microorganisms and is the main substrate for photosynthesis. Several previous studies evidenced that CO2 might play a minor role in the process of plant growth promotion mediated by volatile compounds from fungi or bacteria (Ditengou et al. 2015; Li et al. 2021).
Auxin signaling and transport are essential for B. subtilis WM13-24-stimulated root architecture improvement
Auxin plays essential roles in root system development and root meristem maintenance (Overvoorde et al. 2010; Hu et al. 2021). The auxin distribution in the root tip controls many aspects of root phenotype (Hu et al. 2021). Other phytohormones were shown to regulate LR development through crosstalk with auxin (Ivanchenko et al. 2008; Sharifi and Ryu 2018). López-Bucio et al. (2007) demonstrated that Bacillus megaterium promoted plant growth and altered root architecture may involve auxin- and ethylene independent mechanisms. Arabidopsis root system development upon Martelella endophytica YC6887 colonization was dependent on auxin signaling, but independent of ethylene and jasmonic acid signaling (Khan et al. 2016). Indole emitted by Proteus vulgaris JBLS202 stimulated the growth of Arabidopsis through an interplay between the auxin, cytokinin, and brassinosteroid pathways (Bhattacharyya et al. 2015). Bacillus siamensis YC7012 can promote the growth of Arabidopsis by producing VOCs independent of auxin, ethylene, or jasmonic acid signaling pathway (Hossain et al. 2019). Garnica-Vergara et al (2016) reported that the production of 6-pentyl-2H-pyran-2-one by Trichoderma atroviride directly influences root architecture via modulation of ethylene signaling and auxin transport (Garnica-Vergara et al. 2016). In this study, WM13-24 altered root architecture by stimulating lateral root formation and root hair development, therefore, water and nutrient acquisitions were increased, leading to improved biomass production. the arf7arf19 mutant did not form any LRs in response to VOCs (Fig. 5C), suggesting that VOCs emitted from WM13-24 directly influences auxin response transcription factors AUXIN RESPONSE FACTOR7 (ARF7) and ARF19-mediated auxin signaling pathway in the root of Arabidopsis.
We observed enhanced DR5::GUS and DR5::GFP blue spots and fluorescence after WM13-24 VOCs treatment in the roots, particularly in the apical meristem and LR primordia, indicating that the auxin signaling and auxin distribution were altered by WM13-24 VOCs during the LR initiation program (Fig. 6). Auxin accumulation and distribution were regulated by its biosynthesis and transport (Stepanova et al. 2008; Yamada et al. 2009; Sun et al. 2020). Strain WM13-24 VOCs treatment significantly increased the expressions of IAA biosynthesis-related genes and IAA content in roots (Fig. 7). Our results indicated that WM13-24 VOCs increased the expression of the DR5:GUS and DR5:GFP reporter in root by enhancing auxin biosynthesis.
Polar auxin transport plays important roles to modulate local auxin levels (Blilou et al. 2005; Krecek et al. 2009; Liu et al. 2015; Hu et al. 2021). Treatment with the auxin transport inhibitor NPA affects root growth (Zhang et al. 2007; Zamioudis et al. 2013), and these results suggest that disturbing polar auxin transport changes auxin accumulation in root and subsequently alters root growth (Raya-González et al. 2014). In this study, NPA compromised the ability of WM13-24 to promote LR formation, suggesting that polar auxin transport is involved in WM13-24 VOCs-mediated root growth. Consistent with this result, PIN4-GFP was obviously reduced by WM13-24 VOCs treatment, whereas PIN1-GFP and PIN2-GFP fluorescence were not obviously changed (Fig. 9). PGPR increased LR formation associated with regulated expression of auxin transporters (Garnica-Vergara et al. 2016; Sun et al. 2020). Therefore, these results indicated that PIN4 at least partly was involved in WM13-24 VOCs-induced changes of polar auxin transport in root and root growth. How PIN4 is involved in WM13-24-induced root growth remains to be explored. Taken together, the results demonstrated that the VOCs from strain WM13-24 stimulated lateral root formation by increasing DR5:GUS and DR5:GFP reporter expression in root via enhancement of auxin biosynthesis and PIN4-mediated polar auxin transport.
Benzyl alcohol and 2,3- butanediol are major growth promotion-related VOCs emitted by strain B. subtilis WM13-24
Microbial volatiles are highly diverse and strain-specific (Blom et al. 2011; Lee et al. 2016). The VOCs produced by certain PGPR or PGPF can be used for plant-bacterium communication as plant growth promotion triggers. In recent years, a number of VOCs that increase fresh weight, root length and the number of lateral roots in plants had been identified, such as acetoin (Ryu et al. 2003; Li et al. 2021); 6-pentyl-2H-pyran-2-one (Garnica-Vergara et al. 2016); dimethyl disulfide, dimethyl trisulfide, acetophenone and 3-hexanone (Groenhagen et al. 2013; Cordovez et al. 2018); ethyl isovalerate, isoamyl acetate, 3-methyl-1-butanol, benzyl alcohol, 2-phenylethyl alcohol and 3-(methylthio)-1-propanol (Camarena-Pozos et al. 2019); 3-methylbutanol, dodecyl aldehyde, isovaleraldehyde, isoamyl propionate, isovaleric acid and 2-heptanone (Syed-Ab-Rahman et al. 2019). 2,3-butanediol and acetoin were already reported to promote plant growth and LR development (Ryu et al. 2003; Li et al. 2021). To understand the possible role of VOCs released from WM13-24 in phytostimulation, we monitored VOCs production by strain WM13-24 alone or WM13-24 in the interaction with Arabidopsis seedlings. The results showed that benzyl alcohol and the mixture treatment (combination of benzyl alcohol and 2,3-butanediol) increased LR number, especially benzyl alcohol treatment had higher LR numbers than mixture (Fig. S5; Fig. S6). These results indicated that the effects of VOCs on plant growth and development cannot be simply explained by the arithmetic addition of compounds, because organisms were evolutionarily attuned to relative concentrations of volatiles than to absolute amounts (Sharifi and Ryu 2018). Li et al (2021) reported that acetoin, a major component of Bacillus amyloliquefaciens VOCs, is less active in promoting root development compared to VOC blends from B. amyloliquefaciens (Li et al. 2021). In many cases, exposure of plants to discrete (individual) VOCs or VOC mixtures either failed to reproduce or only partially reproduced the effects induced by the complex blends of VOCs emitted by PGPR (Groenhagen et al. 2013; Naznin et al. 2013; Cordovez et al. 2017; García-Gómez et al. 2019). Our result showed that mixture (combination of benzyl alcohol and 2,3-butanediol) treatment produced fewer LR numbers compared to inoculation with WM13-24.
Our approach to screen for VOCs from WM13-24 involved in growth promotion using Arabidopsis was also effective in host plants H. ammodendron. Benzyl alcohol, 2,3-butanediol and their mixture also promote the growth of desert plant H. ammodendron. This results suggesting that application of the identified volatiles in the field could speed up growth of desert plants. However, it remains to be elucidated how VOCs are perceived by plants and how these signals are interpreted and processed across plant species (Sharifi and Ryu 2018; Camarena-Pozos et al. 2019).
Conclusions
Bacillus subtilis WM13-24 was able to promote the growth of both Arabidopsis and its host plant, Haloxylon ammodendron. B. subtilis WM13-24 inoculation altered the root architecture of Arabidopsis by increasing the number of lateral roots through enhancing auxin accumulation in roots via increased auxin biosynthesis and PIN4-mediated polar auxin transport. Bioactive VOCs emitted by WM13-24 mainly include 2,3-butanediol and benzyl alcohol and they, alone or in combination, promoted growth of both Arabidopsis and its host plant H. ammodendron. Our study suggests that bioactive VOCs from WM13-24 have potential application value in plant production in arid and semi-arid environments.
Data Availability
All data used in the study have been included in the figures, table and supplementary information.
References
Adamowski M, Friml J (2015) PIN-dependent auxin transport: Action, regulation, and evolution. Plant Cell 27:20–32
Aziz M, Nadipalli RK, Xie X, Sun Y, Surowiec K, Zhang JL, Paré PW (2016) Augmenting sulfur metabolism and herbivore defense in Arabidopsis by bacterial volatile signaling. Front Plant Sci 8:7–458
Bailly A, Groenhagen U, Schulz S, Geisler M, Eberl L, Weisskopf L (2014) The inter-kingdom volatile signal indole promotes root development by interfering with auxin signalling. Plant J 80:758–771
Bailly A, Weisskopf L (2017) Mining the volatilomes of plant associated microbiota for new biocontrol solutions. Front Microbiol 8:1638
Beauregard PB, Chai Y, Vlamakis H, Losick R, Kolter R (2013) Bacillus subtilis biofilm induction by plant polysaccharides. Proc Natl Acad Sci U S A 110:1621–1630
Bhattacharyya D, Garladinne M, Lee YH (2015) Volatile indole produced by rhizobacterium Proteus vulgaris JBLS202 stimulates growth of Arabidopsis thaliana through auxin, cytokinin, and brassinosteroid pathways. J Plant Growth Regul 34:158–168
Blilou I, Xu J, Wildwater M, Willemsen V, Paponov I, Friml J, Heidstra R, Aida M, Palme K, Scheres B (2005) The PIN auxin efflux facilitator network controls growth and patterning in Arabidopsis roots. Nature 433:39–44
Blom D, Fabbri C, Connor EC, Schiestl FP, Klauser DR, Boller T, Weisskopf L (2011) Production of plant growth modulating volatiles is widespread among rhizosphere bacteria and strongly depends on culture conditions: Volatile-mediated impact of bacteria on Arabidopsis thaliana. Environ Microbiol 13:3047–3058
Bulgarelli D, Schlaeppi K, Spaepen S, van Themaat EVL, Schulze-Lefert P (2013) Structure and functions of the bacterial microbiota of plants. Annu Rev Plant Biol 64:807–838
Camarena-Pozos DA, Flores-Núñez VM, López MG, López-Bucio J, Partida-Martínez LP (2019) Smells from the desert: Microbial volatiles that affect plant growth and development of native and non-native plant species. Plant Cell Environ 42:1368–1380
Cazorla FM, Romero D, Pérez-García A, Lugtenberg BJ, Vicente Ad, Bloemberg G (2007) Isolation and characterization of antagonistic Bacillus subtilis strains from the avocado rhizoplane displaying biocontrol activity. J Appl Microbiol 103:1950–1959
Chen Q, Liu Y, Maere S, Lee E, Van Isterdael G, Xie Z, Xuan W, Lucas J, Vassileva V, Kitakura S, Marhavý P, Wabnik K, Geldner N, Benková E, Le J, Fukaki H, Grotewold E, Li C, Friml J, Sack F, Beeckman T, Vanneste S (2015) A coherent transcriptional feed-forward motif model for mediating auxin-sensitive PIN3 expression during lateral root development. Nat Commun 18:6–8821
Cordovez V, Mommer L, Moisan K, Lucas-Barbosa D, Pierik R, Mumm R, Carrion VJ, Raaijmakers JM (2017) Plant phenotypic and transcriptional changes induced by volatiles from the fungal root pathogen Rhizoctonia solani. Front Plant Sci 21:8–1262
Cordovez V, Schop S, Hordijk K, Dupré de Boulois H, Coppens F, Hanssen I, Raaijmakers JM, Carrión VJ (2018) Priming of plant growth promotion by volatiles of root-associated Microbacterium spp. Appl Environ Microbiol 84:e01865-e1918
Du Y, Scheres B (2018) Lateral root formation and the multiple roles of auxin. J Exp Bot 69:155–167
Ditengou FA, Müller A, Rosenkranz M, Felten J, Lasok H, van Doorn MM, Legué V, Palme K, Schnitzler JP, Polle A (2015) Volatile signalling by sesquiterpenes from ectomycorrhizal fungi reprogrammes root architecture. Nat Commun 6:6279
Estelle MA, Somerville C (1987) Auxin-resistant mutants of Arabidopsis thaliana with an altered morphology. Mol Genet Gen 206:200–206
Fukaki H, Okushima Y, Tasaka M (2007) Auxin-mediated lateral root formation in higher plants. Int Rev Cytol 256:111–137
Gao HJ, Lü XP, Ren W, Sun YY, Zhao Q, Wang GP, Wang RJ, Wang YP, Zhang H, Wang SM, Meng LS, Zhang JL (2020) HaASR1 gene cloned from a desert shrub, Haloxylon ammodendron, confers drought tolerance in transgenic Arabidopsis thaliana. Environ Exp Bot 180:104251
Garbeva P, Weisskopf L (2020) Airborne medicine: bacterial volatiles and their influence on plant health. New Phytol 226:32–43
García-Gómez P, Almagro G, Sánchez-López ÁM, Bahaji A, Ameztoy K, Ricarte-Bermejo A, Baslam M, Antolín MC, Urdiain A, López-Belchi MD, López-Gómez P, Morán JF, Garrido J, Muñoz FJ, Baroja-Fernández E, Pozueta-Romero J (2019) Volatile compounds other than CO2 emitted by different microorganisms promote distinct posttranscriptionally regulated responses in plants. Plant Cell Environ 42:1729–1746
Garnica-Vergara A, Barrera-Ortiz S, Muñoz-Parra E, Raya-González J, Méndez-Bravo A, Macías-Rodríguez L, Ruiz-Herrera LF, López-Bucio J (2016) The volatile 6-pentyl-2H-pyran-2-one from Trichoderma atroviride regulates Arabidopsis thaliana root morphogenesis via auxin signaling and ETHYLENE INSENSITIVE 2 functioning. New Phytol 209:1496–1512
Groenhagen U, Baumgartner R, Bailly A, Gardiner A, Eberl L, Schulz S, Weisskopf L (2013) Production of bioactive volatiles by different Burkholderia ambifaria strains. J Chem Ecol 39:892–906
He A, Niu S, Yang D, Ren W, Zhao L, Sun Y, Meng L, Zhao Q, Paré PW, Zhang J (2021) Two PGPR strains from the rhizosphere of Haloxylon ammodendron promoted growth and enhanced drought tolerance of ryegrass. Plant Physiol Biochem 161:74–85
He AL, Niu SQ, Zhao Q, Li YS, Gou JY, Gao HJ, Suo SZ, Zhang JL (2018) Induced salt tolerance of perennial ryegrass by a novel bacterium strain from the rhizosphere of a desert shrub Haloxylon ammodendron. Int J Mol Sci 19:469–488
Hobbie L, Estelle M (1995) The axr4 auxin-resistant mutants of Arabidopsis thaliana define a gene important for root gravitropism and lateral root initiation. Plant J 7:211–220
Hossain MT, Khan A, Harun-Or-Rashid M, Chung YR (2019) A volatile producing endophytic Bacillus siamensis YC7012 promotes root development independent on auxin or ethylene/jasmonic acid pathway. Plant Soil 439:309–324
Hu Y, Omary M, Hu Y, Doron O, Hoermayer L, Chen Q, Megides O, Chekli O, Ding Z, Friml J, Zhao Y, Tsarfaty I, Shani E (2021) Cell kinetics of auxin transport and activity in Arabidopsis root growth and skewing. Nat Commun 12:1657
Hua J, Meyerowitz E (1998) Ethylene responses are negatively regulated by a receptor gene family in Arabidopsis thaliana. Cell 94:262–271
Inaji A, Okazawa A, Taguchi T, Nakamoto M, Katsuyama N, Yoshikawa R, Ohnishi T, Waller F, Ohta D (2020) Rhizotaxis modulation in Arabidopsis is induced by diffusible compounds produced during the cocultivation of Arabidopsis and the endophytic fungus Serendipita indica. Plant Cell Physiol 61:838–850
Inoue T, Higuchi M, Hashimoto Y, Seki M, Kobayashi M, Kato T, Tabata S, Shinozaki K, Kakimoto T (2001) Identification of CRE1 as a cytokinin receptor from Arabidopsis. Nature 409:1060–1063
Ivanchenko MG, Muday GK, Dubrovsky JG (2008) Ethylene–auxin interactions regulate lateral root initiation and emergence in Arabidopsis thaliana. Plant J 55:335–347
Jia Z, von Giehl RFH, Wirén N (2021) Local auxin biosynthesis acts downstream of brassinosteroids to trigger root foraging for nitrogen. Nat Commun 12:5437
Kai M, Haustein M, Molina F, Petri A, Scholz B, Piechulla B (2009) Bacterial volatiles and their action potential. Appl Microbiol Biotechnol 81:1001–1012
Kasahara H (2016) Current aspects of auxin biosynthesis in plants. Biosci Biotechnol Biochem 80:34–42
Kauschmann A, Jessop A, Koncz C Szekeres M, Willmitzer L, Altmann T (1996) Genetic evidence for an essential role of brassinosteroids in plant development. Plant J 9:701–713
Khan A, Hossain MT, Park HC, Yun DJ, Shim SH, Chung YR (2016) Development of root system architecture of Arabidopsis thaliana in response to colonization by Martelella endophytica YC6887 depends on auxin signaling. Plant Soil 405:81–96
Krecek P, Skupa P, Libus J, Naramoto S, Tejos R, Friml J, Zazímalová E (2009) The PIN-FORMED (PIN) protein family of auxin transporters. Genome Biol 10:249
Lawton K, Weymann K, Friedrich L, Vernooij B, Uknes S, Ryals J (1995) Systemic acquired resistance in Arabidopsis requires salicylic acid but not ethylene. Mol Plant Microbe Interact 8:863–870
Lee S, Yap M, Behringer G, Hung R, Bennett JW (2016) Volatile organic compounds emitted by Trichoderma species mediate plant growth. Fungal Biol Biotechnol 3:7
Lemfack MC, Gohlke BO, Toguem SMT, Preissner S, Piechulla B, Preissner R (2018) mVOC 2.0: A database of microbial volatiles. Nucleic Acids Res 46:1261–1265
Li T, Kang X, Lei W, Yao X, Zou L, Zhang D, Lin H (2020) SHY2 as a node in the regulation of root meristem development by auxin, brassinosteroids, and cytokinin. J Integr Plant Biol 62:1500–1517
Li Y, Shao J, Xie Y, Jia L, Fu Y, Xu Z, Zhang N, Feng H, Xun W, Liu Y, Shen Q, Xuan W, Zhang R (2021) Volatile compounds from beneficial rhizobacteria Bacillus spp. promote periodic lateral root development in Arabidopsis. Plant Cell Environ 44:1663–1678
Liu W, Li RJ, Han TT, Cai W, Fu ZW, Lu YT (2015) Salt stress reduces root meristem size by nitric oxide-mediated modulation of auxin accumulation and signaling in Arabidopsis. Plant Physiol 168:343–356
López-Bucio J, Campos-Cuevas JC, Hernández-Calderón E, Velásquez-Becerra C, Farías-Rodríguez R, Macías-Rodríguez LI, Valencia-Cantero E (2007) Bacillus megaterium rhizobacteria promote growth and alter root-system architecture through an auxin- and ethylene-independent signaling mechanism in Arabidopsis thaliana. Mol Plant Microbe Interact 20:207–217
Lü XP, Gao HJ, Zhang L, Wang YP, Shao KZ, Zhao Q, Zhang JL (2019) Dynamic responses of Haloxylon ammodendron to various degrees of simulated drought stress. Plant Physiol Biochem 139:121–131
Lv B, Wei K, Hu K, Tian T, Zhang F, Yu Z, Zhang D, Su Y, Sang Y, Zhang X, Ding Z (2021) MPK14-mediated auxin signaling controls lateral root development via ERF13-regulated very-long-chain fatty acid biosynthesis. Mol Plant 14:285–297
Malamy JE, Benfey PN (1997) Organization and cell differentiation in lateral roots of Arabidopsis thaliana. Development 124:33–44
Matsui K (2016) A portion of plant airborne communication is endorsed by uptake and metabolism of volatile organic compounds. Curr Opin Plant Biol 32:24–30
Meldau DG, Meldau S, Hoang LH, Underberg S, Wünsche H, Baldwin IT (2013) Dimethyl disulfide produced by the naturally associated bacterium Bacillus sp. B55 promotes Nicotiana attenuata growth by enhancing sulfur nutrition. Plant Cell 25:2731–2747
Morcillo RJL, Singh SK, He D, Vílchez JI, Kaushal R, Wang W, Huang W, Paré PW, Zhang H (2020) Bacteria-derived diacetyl enhances Arabidopsis phosphate starvation responses partially through the DELLA-dependent gibberellin signaling pathway. Plant Signal Behav 15:1740872
Naznin HA, Kimura M, Miyazawa M, Hyakumachi M (2013) Analysis of volatile organic compounds emitted by plant growth promoting fungus Phoma sp. GS8-3 for growth promotion effects on tobacco. Microbes Environ 28:42–49
Osmont KS, Sibout R, Hardtke CS (2007) Hidden branches: developments in root system architecture. Annu Rev Plant Biol 58:93–113
Overvoorde P, Fukaki H, Beeckman T (2010) Auxin control of root development. Cold Spring Harb Perspect Biol 2:a001537
Péret B, De Rybel B, Casimiro I, Benková E, Swarup R, Laplaze L, Beeckman T, Bennett MJ (2009) Arabidopsis lateral root development: an emerging story. Trends Plant Sci 14:399–408
Perez-Flores P, Valencia-Cantero E, Altamirano-Hernandez J, Pelagio-Flores R, Lopez-Bucio J, Garcia-Juarez P, Macias-Rodriguez L (2017) Bacillus methylotrophicus M4–96 isolated from maize (Zea mays) rhizoplane increases growth and auxin content in Arabidopsis thaliana via emission of volatiles. Protoplasma 254(6):2201–2213
Piechulla B, Lemfack MC, Kai M (2017) Effects of discrete bioactive microbial volatiles on plants and fungi: Discrete bioactive mVOCs. Plant Cell Environ 40:2042–2067
Qu Q, Zhang Z, Peijnenburg WJGM, Liu W, Lu T, Hu B, Chen J, Chen J, Lin Z, Qian H (2020) Rhizosphere microbiome assembly and its impact on plant growth. J Agric Food Chem 68:5024–5038
Raya-González J, Ortiz-Castro R, Ruíz-Herrera LF, Kazan K, López-Bucio J (2014) PHYTOCHROME AND FLOWERING TIME1/MEDIATOR25 Regulates lateral root formation via auxin signaling in Arabidopsis. Plant Physiol 165:880–894
Raza W, Wei Z, Jousset A, Shen Q, Friman VP (2021) Extended plant metarhizobiome: understanding volatile organic compound signaling in plant-microbe metapopulation networks. MSystems 6:e0084921
Roman G, Lubarsky B, Kieber JJ, Rotheneberg M, Ecker JR (1995) Genetic analysis of ethylene signal transduction in Arabidopsis thaliana: five novel mutant loci integrated into a stress response pathway. Genetics 139:1393–1409
Ryu CM, Farag MA, Hu CH, Reddy M, Wei HX, Paré PW, Kloepper JW (2003) Bacterial volatiles promote growth in Arabidopsis. Proc Natl Acad Sci U S A 100:4927–4932
Sasse J, Martinoia E, Northen T (2018) Feed your friends: Do plant exudates shape the root microbiome? Trends Plant Sci 23:25–41
Schulz-Bohm K, Martín-Sánchez L, Garbeva P (2017) Microbial volatiles: Small molecules with an important role in intra-and interkingdom interactions. Front Microbiol 8:2484
Sharifi R, Ryu CM (2018) Revisiting bacterial volatile-mediated plant growth promotion: lessons from the past and objectives for the future. Ann Bot 122(3):349–358
Spaepen S, Bossuyt S, Engelen K, Marchal K, Vanderleyden J (2014) Phenotypical and molecular responses of Arabidopsis thaliana roots as a result of inoculation with the auxin-producing bacterium Azospirillum brasilense. New Phytol 201:850–861
Staswick PE, Serban B, Rowe M, Tiryaki I, Maldonado MT, Maldonado MC, Suza W (2005) Characterization of an Arabidopsis enzyme family that conjugates amino acids to indole-3-acetic acid. Plant Cell 17:616–627
Stepanova AN, Robertson-Hoyt J, Yun J, Benavente LM, Xie DY, Dolezal K, Schlereth A, Jürgens G, Alonso JM (2008) TAA1-mediated auxin biosynthesis is essential for hormone crosstalk and plant development. Cell 133:177–191
Stotz HU, Jikumaru Y, Shimada Y, Sasaki E, Stingl N, Mueller MJ, Kamiya Y (2011) Jasmonate-dependent and COI1-independent defense responses against Sclerotinia sclerotiorum in Arabidopsis thaliana: Auxin is part of COI1-independent defense signaling. Plant Cell Physiol 52:1941–1956
Sun X, Wang N, Li P, Jiang Z, Liu X, Wang M, Su Z, Zhang C, Lin F, Liang Y (2020) Endophytic fungus Falciphora oryzae promotes lateral root growth by producing indole derivatives after sensing plant signals. Plant Cell Environ 43:358–373
Syed-Ab-Rahman SF, Carvalhais LC, Chua ET, Chung FY, Moyle PM, Eltanahy EG, Schenk PM (2019) Soil bacterial diffusible and volatile organic compounds inhibit Phytophthora capsici and promote plant growth. Sci Total Environ 692:267–280
Timpte C, Wilson AK, Estelle M (1994) The axr2-1 mutation of Arabidopsis thaliana is a gain-of-function mutation that disrupts an early step in auxin response. Genetics 138:1239–1249
Van de Poel B, Smet D, Van Der Straeten D (2015) Ethylene and hormonal cross talk in vegetative growth and development. Plant Physiol 169:61–72
Verbon EH, Liberman LM (2016) Beneficial microbes affect endogenous mechanisms controlling root development. Trends Plant Sci 21:218–229
Vílchez JI, Yang Y, He D, Zi H, Peng L, Lv S, Kaushal R, Wang W, Huang W, Liu R, Lang Z, Miki D, Tang K, Paré PW, Song CP, Zhu JK, Zhang H (2020) DNA demethylases are required for myo-inositol-mediated mutualism between plants and beneficial rhizobacteria. Nat Plants 6:983–995
Wang A, Hua J, Wang Y, Zhang G, Luo S (2020) Stereoisomers of nonvolatile acetylbutanediol metabolites produced by Bacillus velezensis WRN031 improved root elongation of maize and rice. J Agric Food Chem 68:6308–6315
Wang CM, Xia ZR, Wu GQ, Yuan HJ, Wang XR, Li JH, Tian FP, Zhang Q, Zhu XQ, He JJ, Kumar T, Wang XL, Zhang JL (2016) The coordinated regulation of Na+ and K+ in Hordeum brevisubulatum responding to time of salt stress. Plant Sci 252:358–366
Xie DX, Feys BF, James S, Nieto-Rostro, Turner, JG (1998) COI1: An Arabidopsis gene required for jasmonate-regulated defense and fertility. Science 280:1091–1094
Xu YY, Lu H, Wang X, Zhang KQ, Li GH (2015) Effect of volatile organic compounds from bacteria on nematodes. Chem Biodivers 12:1415–1421
Yamada M, Greenham K, Prigge MJ, Jensen PJ, Estelle M (2009) The TRANSPORT INHIBITOR RESPONSE2 gene is required for auxin synthesis and diverse aspects of plant development. Plant Physiol 151:168–179
Zamioudis C, Mastranesti P, Dhonukshe P, Blilou I, Pieterse CM (2013) Unraveling root developmental programs initiated by beneficial Pseudomonas spp. bacteria. Plant Physiol 162:304–318
Zhang H, Kim MS, Krishnamachari V, Payton P, Sun Y, Grimson M, Farag MA, Ryu CM, Allen R, Melo IS, Paré PW (2007) Rhizobacterial volatile emissions regulate auxin homeostasis and cell expansion in Arabidopsis. Planta 226:839–851
Zhou JY, Li X, Zheng JY, Dai CC (2016) Volatiles released by endophytic Pseudomonas fluorescens promoting the growth and volatile oil accumulation in Atractylodes lancea. Plant Physiol Biochem 101:132–140
Acknowledgements
We thank Prof. Chuan-You Li, Lai-Sheng Meng, Hong-Ju Yin and Dr. Hai-Qing Liu for kindly providing mutants. This work was supported by the National Natural Science Foundation of China (grant No. 32071875), the National Key Research and Development Program of China (grant No. 2019YFC0507703), the Leading Scientist Project of Qinghai Province (grant No. 2023-NK-147), and the Independent Research and Development Project of State Key Laboratory of Herbage Improvement and Grassland Agro-ecosystems (grant No. 202203).
Author information
Authors and Affiliations
Contributions
Jin-Lin Zhang conceived the project and planned the experiments. Ao-Lei He, Wei Ren, Hui-Ru Li and Ling-Yu Zhao carried out the experiments. Ao-Lei He and Wei Ren analyzed the data. Ao-Lei He and Jin-Lin Zhang wrote the manuscript., Paul W. Paré and Qi Zhao revised the manuscript.
All authors are aware with the content of the manuscript and have agreed with the submission to Plant and Soil. The manuscript is not currently being considered for publication in another journal and the manuscript has not been published in whole or in part elsewhere.
Corresponding authors
Ethics declarations
Conflict of interest
The authors declare that they have no conflict of interest.
Human and animal rights
This article does not contain any studies with human or animal subjects.
Additional information
Responsible Editor: Tim S. George.
Publisher's note
Springer Nature remains neutral with regard to jurisdictional claims in published maps and institutional affiliations.
Supplementary Information
Below is the link to the electronic supplementary material.
Rights and permissions
Springer Nature or its licensor (e.g. a society or other partner) holds exclusive rights to this article under a publishing agreement with the author(s) or other rightsholder(s); author self-archiving of the accepted manuscript version of this article is solely governed by the terms of such publishing agreement and applicable law.
About this article
Cite this article
He, AL., Zhao, LY., Ren, W. et al. A volatile producing Bacillus subtilis strain from the rhizosphere of Haloxylon ammodendron promotes plant root development. Plant Soil 486, 661–680 (2023). https://doi.org/10.1007/s11104-023-05901-2
Received:
Accepted:
Published:
Issue Date:
DOI: https://doi.org/10.1007/s11104-023-05901-2